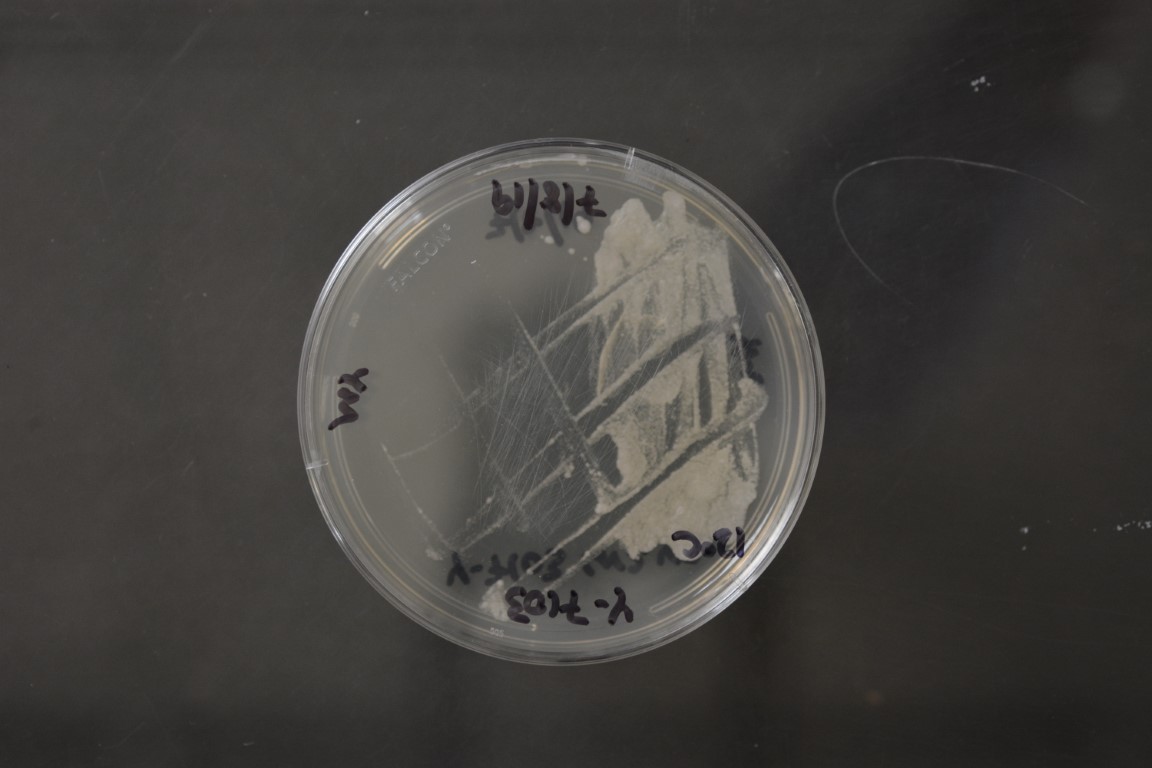

Mrakia frigida
NRRL Y-7103(Type Strain)
Accession numbers in other collections:ATCC 22029=CBS 5270=di Menna 5AI=IAM 14136=IFO 1920=JCM 7857=Komagata YK 100=Komagata YK 1006=ML-90=NCYC 704=VKM Y-1455=Y-7202
Source:F.J.Fell,RSMAS,University of Miami,Florida
Isolated from(substrate):SL,soil
Substrate location:Scott Base,Antarctica
Genetic info:GenBank:D1/D2(AF075463),ITS(AF144483),SSU(D12802),RPB1(KF036511),RPB2(FK036925),TEF1(KF037186).
Growth media:Yeast Extract-Malt Extract-Peptone-Glucose(YM for yeasts)(number 6)
Optimum growth temperature:12C
Strain images:
NRRL_Y-7103_6.JPG